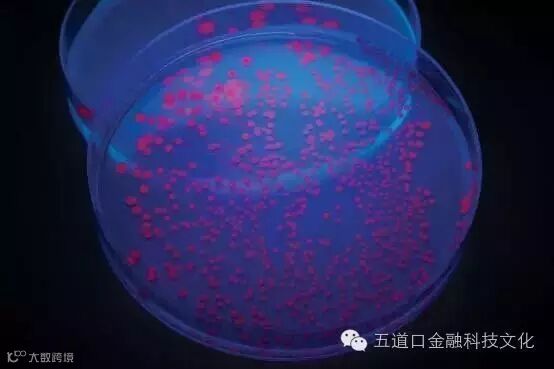

身着太空服,站在一扇巨大门前的人
有一个十分著名的说法,“新闻不过是历史最初的、粗糙的草稿”。近日,作为科学新闻届的标杆,年满60岁的《新科学家》杂志则稍有不同。
本月16日,作为60周年纪念,《新科学家》重磅发布了最新一期的杂志,试图为其读者提供“第一份关于未来的草图”。
在过去 60 年里,这本全球顶级的科学杂志不仅报告了哪些科学技术的新发明和新发现,还试图解释它们的重要性,以及它们将如何引领时代变革。
无疑,这不是一份容易的工作。可验证的预测、严谨的猜测与凭空想象之间只有一线之隔。
在这份未来预测报告中,《新科学家》并不认为预测未来是件十分靠谱的事情,甚至指出很多未来学注定是失败的,因为随着系统变得更加复杂,精确的预测会变得更加困难。
比如,当下有很多预测认为,人类将最终面临一个技术奇点,而身处该点的超级智能机器将在技术的跑道上狂奔,并带来难以预料的后果。
无疑,《新科学家》并不认同所谓技术奇点是存在的,甚至认为这种说法已经被拔高到能够控制所有相关事物的自然定律高度。
这本著名杂志指出,摩尔定律不是一种自然规律,而是一个自我实现的预言,它之所以能够实现,是因为人们一直努力的试图让其实现。现在人们逐渐陷入困境了,因为自然的实际法则开始干预。
因此,可以推论,虽然目前的AI研究速度令人惊叹,但之后的道路也一定会有着许多的坎坷。
然而,《新科学家》依然是一本保持乐观态度的出版物。他们认为,人类必须让这个世界变得最好,这也就是人类一直在努力做的事情。而只有不断去思考未来,人类才会成功。
正是本着这种精神,《新科学家》选择了几个至少当下看起来还显得合乎情理的场景,从而能够严谨地猜测未来 60 年可能发生的事。
虽然未来几乎肯定不会像这份指南所描述的那样,但如果你依然想对未来的60年有所畅想,这无疑是一期不能错过的杂志。以下是此份权威报告的部分精彩选编,仅供大家参考。
2076年的世界:任何我们想要的现在都可以轻松实现

想象一个没有稀缺的世界其实是出人意料的困难。
澳大利亚布里斯班昆士兰大学经济学家约翰·奎金说,当我们考虑物质需求的终结时,我们通常仅仅考虑了自身。但是如果当所有人的需求都已经得到了满足呢?
“稀缺是我们基本经济制度的基础,”他说。 这是资本主义范式,其原则对我们大多数人来说,就像是物理定律那样不可协商。如果一切都是免费的,那么经济如何运作?如果没有人能够得到工资,谁还会做事情?这不就是共产主义吗?试图想象一个不是围绕着市场组织起来的世界,有点像一条鱼在思考水之外的世界是什么样的。
杰瑞米·瑞夫金(Jeremy Rifkin)在2014年的宣言“零边际成本社会”对此进行了设想。
他认为,资本主义几乎已经完全吞噬了自己。“这是市场的终极胜利”,最后社会会过渡到这个样子:自动化将使得生产每一件额外产品的边际成本接近于零,产品基本上是免费的。
想要体会一下这究竟是一个什么样的世界?
让我们想一想音乐和出版业。互联网已经使内容的生产和分发非常便宜。虽然对一些人来说这一过程有些痛苦,瑞夫金则认为这种趋势是预兆了一种新型的范式,而且这种范式将蔓延到所有的其他行业。
创造这一可能的关键将是一个可以几乎满足任何需求的制造设备:有点像当下的3D打印机,但实际上要比它复杂得多,而它与3D打印机的差距,大概就像一个现代计算机与20世纪60年代的电子计算器那样大。
在 60 年内,这些设备可能已经演变成名为分子组装器的机器。这一术语是由埃里克·德雷克斯勒(Eric Drexler)于 1977 年创造的。
他想象了一个纳米制造装置,能够以足够的速度和精度操纵单个分子,并能够生产任何你想要的物质。按下按钮,等待一段时间,就能生产出来食品、药品、服装、自行车零件或任何东西,同时仅需耗费极少的资金或劳动力。
当然,我们还不确定这样的世界会变成什么样子——但是轮廓正在显现。瑞夫金认为,制造商将是共享经济的引擎。所有权的概念将让于使用权(想一想Spotify和Uber所做的一切),购买则将让位于一台能够打印任何你所需要的机器。
在20年内,资本主义将不再是经济生活的独家仲裁者。它将与它的继承者分享这一舞台。
在60年内,资本主义可能会完全消失。到那时,我们的社会可能能够满足我们所有的基本需求。瑞夫金将他的新经济愿景称为“公共社会(the commons)”,但它不仅仅囊括了经济方面的变革,它还将是我们嬉戏的新“水池”。
届时,你将会有一份工作,但你工作不是为了钱。 你工作的公司将是一个非营利组织。你的“财富”衡量标准是你的社交资本:你作为这个种群之中一个合作成员所拥有的声誉。
所以,当你将改良一个小部件的代码开源,你得到的“付款”方式是提升的声誉。专门的应用程序会追踪你对公共资源的贡献——无论是通过您在工作中的投入,节省能源的使用,还是其他度量声誉的方式——都可以让你可以偶尔挥霍一下你积攒的人品点数。
然而,即使在公共社会,我们仍然是人类。
2076年的世界:那场核战争有点令人沮丧

军刀在莫斯科和华盛顿之间再次霍霍作响,更不用提及印度和巴基斯坦在克什米尔的战斗。中国的核武库正在增长。有些人仍然担心伊朗的核意图。朝鲜也拥有了核力量。冷战可能已经结束,但是武器和地缘政治闪点仍然存在。未来60年里有可能发生核战争吗?
世界上仍然拥有大约1万枚核弹头,绝大多数在俄罗斯和美国。但让我们假设这两个国家不按下按钮,紧张局势最终在印度和巴基斯坦之间爆发。
大多数远离南亚的人可能会以为这样的冲突不会对他们造成太大的威胁。恐怕你还需要再好好考虑一下。两国之间只有200多个相对较小的核弹头。假设他们释放了一半,即一百枚15千吨当量的原子弹,这些原子弹的威力与1945年在广岛投下的小男孩相当。
爆炸、风暴与辐射将造成卡拉奇和德里这样的大城市中数百万人死亡。但是,根据新泽西罗格斯大学的阿兰罗勃克(Alan Robock)和科罗拉多州博尔德国家大气研究中心的麦克米尔斯(MichaelMills)的模拟,这只是一个开始。
火灾将把大约500万吨热黑烟送上平流层,随后它们将传播到世界各地。这种烟雾会将到达地球表面的太阳辐射减少8%,足以使北美,欧洲和亚洲大部分地区的平均冬季气温下降2.5至6摄氏度,而不只是几天。而这一影响到达峰值需要大约五年的时间,并且在十年后,地球上的人类仍然会强烈地感受到影响。
除了核冬天之外,气候模型还预测,随着天气系统失去能量,降雨量将减少。 亚洲季风将崩溃:这将影响20亿人,而这些人的用水将减少80%。
同时,亚马逊盆地和已经十分干旱的美国西南部和西澳大利亚几乎也不会好到哪里去。
烟雾会将正常寒冷的平流层加热约30°C,释放含氮化学物质,从而破坏大部分臭氧层。但皮肤癌可能还远远不是我们最为忧虑的一点。
接近冰河时期的温度将导致霜冻,从而世界中纬度主要产粮区的生长季节将减少长达40天。与减少的降雨量和暴增的紫外线一起,这将导致作物产量直线下降。核冬天将带来全球饥荒。
而我们需要记住,所有的这一切,仅仅是从一个微小的区域战争开始的。密苏里大学的史蒂文·斯塔尔(Steven Starr)计算,美俄之间的核交换可以向空气中投射1.5亿吨烟雾。这将阻挡70%的阳光,并使世界大部分地区降温20摄氏度或更多。食物无法生长,大多数人将会饿死。
过去60年来最伟大的地缘政治成就之一是避免核战争。所以,让我们为我们下一个60年祈祷。
2076年的世界:我们还没有发现外星人

几十年以来,我们用着越来越精密的仪器,试图在苍茫宇宙中,寻找我们并不孤单的证据。漫游车正在探索火星的表面,而科学家也正在计划访问其他有希望的地点,比如土星的卫星恩克拉多斯和木星的卫星欧罗巴,两者都可能含有液态水。
预计于2018年发射的詹姆斯·韦伯空间望远镜将使得天文学家们可以对行星大气进行采样,寻找构成生命的化学信号。而射电天文学家长期以来则一直在监听智能外星人的传输信号。
到目前为止,我们什么都还没有发现。如果一直是这样怎么办?如果到本世纪中叶,我们已经访问了太阳系中的每一个有可能存在生命的地方,监听了上亿颗恒星的无线电信号,并观察了数以百万计的外行星,却仍然没有发现最微小的生命轨迹呢?我们什么时候应该放弃,并承认我们是孤独的?
决不,那些参与搜索工作的人这样回答道。“我甚至不能想象什么时候该放弃”,美国宇航局天体生物学计划主任玛丽·沃特克(Mary Voytek)说。 “考虑到那么多围绕着所有其他行星旋转的其他行星,我们无法想象生命不会在别的地方出现。”
毕竟,在已知的宇宙中有大约1000亿个星系,而每个星系里大约包含有1000亿颗恒星。这样庞大的数字使得那些看上去非常不可能的事件最终在某个地方发生,而且生命的起源甚至可能还称不上是完全不可能的。
没有找到外星生命只会使得搜索者们怀疑他们的方法和假设,而不会动摇他们对于目标存在的看法。
加拿大维多利亚大学的天文学家约翰威利斯,他刚刚出版了一本有关寻找外星人生命的新书,这样评论道,“你必须认真思考你如何定义生命。”
现实并不像在星际迷航中那样,你拥有一个三度仪,而当你指向一个生物时,你能听得到很大一声“bong!”。例如,我们可以在外星系的大气中寻找水和氧气。
但谁也不能保证,外星生物需要那些分子。我们可以监听一个外星文明的无线电信号,但谁能保证他们没有更好的沟通方式,而我们却不知道?
即使在外行星上存在着生命,我们也不太可能知道它,除非生命数量能丰富到足以改变整个大气层。如果今天的搜索遇到的是寂静的回应,研究人员将只是回到他们的绘图板前,设计一种更好,更敏感的探测方式,供下次使用。
当然,他们也有可能是错的,也许我们真的是完全孤独。尽管这其中的唯一性让人难以置信,而且极不可能。
而如果真的是这样,科学家可能不得不重新思考他们关于生命起源所需条件的看法,以及为什么地球如此独一无二。威利斯说,这会带来很大的负担。
“如果宇宙真的是空的,而我们是第一个智慧生物,那我们有必须肩负起一个巨大的责任,要好好活着,不要作死。”
2076年的世界:无需能源的人造太阳

2076年,我们已经生活在一个由核聚变供能的世界里。但不幸的是,反应堆离我们仍然有1.5亿公里的距离,依旧十分遥远,而且我们还没有找到一种可以直接利用它的有效方式。
所以,我们依旧在燃烧那些以化石态贮存起来的能源——煤炭、石油和天然气——我们这是在慢慢地煮沸这颗星球,就像温水煮青蛙那样。
回到当下,在地球上再造一个太阳将大大地有助于推进这个问题的解决,但这是一个巨大的难题。
早在60多年前研究就已经开始了,目前最被看好的融合反应堆设计托卡马克,已经面世了半个多世纪了。托卡马克装置将重氢同位素捕获在环形磁场内,通过加热和挤压等离子体使得氘和氚发生聚变以释放能量。
在测试了一系列尺寸越来越大的托科马克装置之后,核聚变研究人员于10年前一致同意在法国建立一个巨大的托科马克装置,即ITER。
如果一切都按照计划——当然这几乎肯定不会发生——那么在2035年,ITER将在数百秒内产生500兆瓦的能量,这将让其成为世界上第一个生成的能量高于运行所需能量的核聚变反应堆。
但通用原子公司副总裁兼美国DIII-D核聚变项目主任米奇·韦德(Mickey Wade)表示,即使到那时,仍然存在两个巨大的障碍——其中之一是开发能够承受长时间暴露于等离子体的材料;另一个是维持约束等离子体运动所需的超强磁场。
克服所有这两个难题将是一个划时代的突破。核聚变将使我们几乎无需再仰赖化石燃料,并能提供几乎无限量的清洁而且极其便宜的能源。
不过真的是这样吗?核聚变当然一定比燃烧化石燃料更加清洁,但它并不是碳中性的。反应堆不会直接排放二氧化碳,但其建造、燃料生产和废物管理过程无可避免地具有自己的碳足迹。
此外,核聚变还会产生放射性废物,即使它们的半衰期是几十年,而不是几百年或者上千年。
同时,核聚变能源也不会便宜。反应堆的建造成本是天文数字般昂贵——ITER项目耗资已经膨胀到超过200亿欧元。
如果无法收回投资,没有人还会再花那么多钱。不过一旦开始运行,其运营成本将在一个适度的范围内。海洋含有够聚变反应堆使用数万年的氘,尽管氚在自然界中极其罕见。
整个世界是否都能运行在核聚变能源之上?原则上是的,但在实践中,这是不可能的。
核聚变工厂的运营商们在运行时,可能仅仅维持在其收回投资的水平,因此核聚变电站输出的电能可能仅满足大部分基本负载功率的需求。
而在面对峰值需求时,则可能必须通过储能技术来满足,例如超级电容器、由太阳能和风能充电等。但我们还必须考虑为飞机以及其他不能直接通过电网运行的技术提供能源的新途径。
然而,核聚变在将来的60年间仍然只是一项未来技术,而太阳能和风能也不太可能满足我们所有的需求。
在这种情况下,我们默认选项仍然可能只有是核裂变,并且继续容忍其所有的弊端——事故、长半衰期放射性废物和武器扩散的担忧。超导材料和地球工程可能是我们的救星。但即使这样,我们在2076年真的需要大量的自制太阳光。
2076年的世界:行走在地球上的人造生命
几乎自地球冷却到可以栖息伊始,地球上就出现了生命,而且就我们所知,这一过程在随后的40亿年岁月里没有再次出现。
但是,随着研究人员们正日益接近从零开始在实验室制备生物这一目标,这一长期的干涸咒语可能在未来的几年内就将宣告结束。
遗传学家已经合成了定制的基因组并将其插入细菌中。他们还改变了其他细菌的遗传密码,使得它们能够使用新的、且是非天然的基础材料来制造蛋白质。
但所有这些努力都是从一个有生命的有机体开始,科学家所做的只是在此基础上加以改良。
一个更为雄心勃勃的研究方向则从无生物活性的化学成分开始——有时是熟悉的核酸和脂质,但有时则是完全不同的结构,比如自组装金属氧化物。
研究人员的目的是使得这些化学物质能够超过达尔文阈值,并开始自我复制并发展:而这是将其称为活性系统的关键标准。如果能够实现这一点,其影响将是巨大的。
最为根本的是,生命合成将补上始自达尔文的哲学上的一处漏缺,即以创造为中心的观点看待生物世界。俄勒冈州波特兰里德学院哲学家马克·贝多(Mark Bedau)说:“这将证明生命只是一个复杂的化学系统。
当然,大多数科学家已经持有这样的观点,但合成生命将使这一点以一种无法被忽视的方式在更广阔的世界呈现出来。
此外,在实验室中创造生命,还将证明生命的起源门槛相对较低,从而增加了我们可能在太阳系中其他地方搜寻到生命的可能性。”
第二次创世纪也将给生物学家一个独立的比较参考点,用以了解究竟是什么使生命开始起源。
而且,因为能够实现合成生命,因此我们还能够修改这一过程,改变成分,以了解究竟哪些功能是真正必须的。
佛罗里达的应用分子进化基金会的史蒂芬·本纳(StevenBenner)说,我们最终称之为“自然生物”的东西被数十亿年的进化所拖累,让我们无法区分出哪些是对于生命真正至关重要的东西,以及哪些是对于我们的特殊行为至关重要的东西。新创造的生命将为实验者们研究生命的必需品提供一个更清洁的系统。
而在未来,现实中的回馈可能还会更进一步。
一开始,任何的新生命形式都是如此脆弱,离开了实验室的悉心照料,生命根本无法存活,所以想要生产特定的分子或者降解有毒废物的生物技术人员,需要更青睐于改善自然生物以获得更好的成功率。
然而,从长远来看,人工生命可能会强大到足以自己茁壮成长。如果真的是这样,它将使得生物技术人员摆脱自然生物的限制,并实现新的目标。“我们可以探索各种可能的回报,”英国格拉斯哥大学的李克·罗宁(Lee Cronin)说。
但是,这些益处还有可能带来风险。根据定义,一种自由生长、独立发展的生命形式将不再完全可预测或可控制。
生物技术人员将需要设计有效的“杀伤开关”,以防新生物以某些方式变得致病或有害,而政策制定者和伦理学家们则需要通力合作,研究何时以及应该如何触发它们。
而公众们则可能一如既往地指责研究人员试图扮演上帝,并或许会试图扼杀整个行业。总之,关于合成生命的影响的讨论需要尽快开始。“在很短的时间内,这就有可能会成为一个严重的问题,”贝多说。
2076 年的世界:转基因人类遍布全球

2021 年 4 月的一天,山田太郎(TarouYamada)出生于东京,并立即成为世界各地的头条新闻。一些报纸这样称呼他为“奇迹男孩”。这是因为太郎的父亲由于Y染色体上存在突变,而不能产生精子,因此,在理论上他是完全不育的。然而,基因测试证实太郎确实是他的儿子。
为了让太郎的故事成为可能,一个生育临床中心需要从太郎父亲处取得干细胞,并使用CRISPR基因组编辑工具去修复他的Y染色体突变,然后将从修复后的细胞中获取精子细胞。那些经过编辑的精子细胞,随后在太郎母亲的卵子细胞中孕育,将基因改变固化到他所有的核DNA之中。换句话说,山田太郎将是第一位基因组被编辑了的人。
他将不会是最后一个。尽管一些国家在听到太郎出生的新闻(日本目前没有这样的法律)之后收紧了禁止基因组编辑的规定,其他国家则认为这样做有理可循,例如允许不育的父母拥有生物学上的自己的孩子。
很快,每年都有几十个基因组编辑过的孩子出生,随后这个数字增加到几百,最后成千上万。你无法将这些孩子从同龄的孩子中区分出来,因为他们的基因组是完全正常的。
这就是胚系基因组编辑革命一种可能的开始方式。现在有很多关于编辑可遗传DNA的讨论,以防止儿童从他们的父母处获得诸如囊性纤维化等疾病的基因,但是,几乎所有这些疾病已经可以通过在植入前筛选IVF胚胎来预防。
为什么那些即将为人父母的人们更青睐于基因组编辑手段,即使所谓的植入前基因诊断却是一种更为安全和便宜的手段——PGD(Preimplantation Genetic Diagnosis,移植前基因诊断)一次只能除去一个或两个有害的突变。而基因编辑技术则一次可以进行几十个变化。
一旦胚系编辑技术开始用于不育治疗,生育门诊可能还同时会提供调整其他基因的选项。遗传工程的反对者将这称为滑坡;但是在支持者眼中,这一手段是明智的,甚至带来了人道主义的进步。
我们每一个人都带有数百个有害的突变,这些突变会增加我们患癌症、阿尔茨海默病以及精神障碍等疾病的风险,所以你既然已经要接受基因组编辑治疗,为什么不顺便解决这些最坏的疾病?
事实上,一旦这些治疗技术可以确保安全地完成,你不去做这些治疗反而可以说是不道德的。
除此之外,人体中还有不少有益的基因变体,其中的一些可能可以使得人们能免疫艾滋病毒或者不太容易变成肥胖。也许最快在2030年代,部分国家就有可能允许引入这些变体。
这种干预将是极具争议的。这种争议性变得尤甚,特别是当我们添加的基因变体能够改善我们高度重视的个性、智力或其他特质时。
然而,我们还不知道如何做到这一点?我们还没有发现任何单一的基因变异,能使得像智商提高的幅度能够媲美有富裕的父母或接受良好的教育。
事实上,大脑是如此复杂,我们可能永远无法预测某个特定突变到底将带来什么结果。
这意味着,引入一个自然界尚未存在的改变大脑的突变,不亚于是黑暗中一个巨大的飞跃,无论是父母或监管者都不应该允许这种飞跃的存在。
但是,基因组编辑技术肯定会让个体不太易患上各种疾病。随着基因组编辑的孩子比那些传统方式怀上的孩子更加健康,富有的父母将开始更加青睐基因组编辑技术,即使他们并没有这样做的迫切需要。
这是否会使得精英人群们能够给他们的孩子平添另一个优势,并扩大富人与穷人之间本义巨大的鸿沟?非常很可能。
但是,让我们以一个乐观的预测作为结尾:在《新科学家》杂志诞生120周年之际,许多国家将常态化地、而且毫无异议地为任何想要这样做的未来父母们提供基因组编辑技术,因为这项技术的治疗成本将远远低于超过一个人一生之中医疗费用的支出。
2076年的世界:我们认为,涵盖一切的理论都在这里

让我们不要自欺欺人:我们现在所认知的一切,都没有逼近事物的真相。
在探寻自然基本理论的过程中,历史带给我们的教训既令人沮丧,又让人欣喜。
拿牛顿的万有引力定律来说,在长达两个多世纪的时间里,它能够十分精确地描述从树上掉下的苹果以及行星的旋转轨迹,但最终它让位于一个“更加正确”的理论,即爱因斯坦的广义相对论。
这一理论与经典力学的直观轮廓相似:但是挖掘到亚原子粒子的水平,我们发现这一理论在量子不确定性的迷雾中变得模糊不清。
量子理论解释了物质在微小规模上的机制,而广义相对论则描述了宇宙的大规模演化。每个理论都有其非常合理之处,但两者之间疏漏和不一致的存在使我们相信,他们也只是未来更好的理论的“占位符”。
一个统一的“涵盖一切的理论”将把我们带到量子论和相对论无法解释的地方,比如说,黑洞之后的究竟会发生什么,或者什么是宇宙的第一种物质。
毫无疑问这些东西让人头疼——许多著名的科学家已经在追求这一终极理论的过程中败下阵来。爱因斯坦的晚年岁月主要用于追寻一个孤立的终极启示,但是最终毫无结果。
当然,现在的事情并没有发生太多的改变。为了实现理论的大一统,试过通过用微小的扭曲弦来替代基本粒子的弦理论已经被提出,尽管人们仍然对它缺乏可测试的预测能力提出了批评。
而一些与之竞争的理论,如环圈量子重力学(loopquantum gravity)等已经开始崭露头角,但尚未带来重大突破。
这是未来60年的凶兆?自20世纪60年代末以来一直在研究能够大一统理论的伦敦帝国学院学者迈克·达夫(Mike Duff),则对于还需要多久才能得到满意的结果表现得出人意料的乐观,“我对于做预测一直抱有怀疑的态度,”他说,“但如果你一定要我给个数字,我会说这将需要10年以上,但不到100年。
环圈量子重力学的领军人物,法国艾克斯马赛大学(Aix-MarseilleUniversity)的卡洛罗维利(Carlo Rovelli),也同样对此表示乐观。“在我看来,在未来六十年里,我们将拥有一个解释量子力学的终极理论”,他说道。
如果真如他们所言,那这将仅仅是一个开始,而不是结局。一种理论只能逐渐地积累信誉。广义相对论的一些预测,如黑洞和引力波,直到20世纪60年代才得到充分的认识和探索。今年早些时候,引力波的存在终于得以实验证实。
让统一理论变得更加复杂的问题在于,它会引入难以置信的高能量,能量之高使得我们的智慧甚至无法重现。即使能够获取实验证明,也很有可能是微弱而间接的。举个例子来说,这些特定的信号可能存在于宇宙微波背景中,而宇宙微波背景是大爆炸之后残留的辐射形式。
基于相同因素,将理论立即转化为现实利益也几乎是不可能的,尽管我们永远也不要说绝不可能。罗维利说,“我现在还看不到这一理论的技术应用。但是在20世纪70年代,当我开始学习广义相对论时,没有人想象过GPS。”
所以不要指望任何灵机一动的时刻,这是一场更为悠久、更为缓慢的进化。但同样的,我们仍要期待一些意想不到的事有可能会发生。
当保罗·迪拉克为了提供一个电子的完整描述,而在20世纪20年代将量子理论与爱因斯坦的狭义相对论统一在一起之时,他忽略了他的方程能够预测另一类、几乎相同的粒子。
几年后,正电子的发现向我们揭示了一个我们尚未能完全探索的新世界——反物质。
例如,涵盖了所有事物的弦理论,可能能够证明存在着另一个宇宙的“多元宇宙”,这将大大扩展我们希望能够了解的事物范畴。
达夫说,这是追逐真理中的乐趣所在,“大多数科学家的目标都是成为游戏大师,而理论物理学家则仍在试图理解游戏。”
2076年的世界:数千人已经定居在火星上

今年是2066年。太阳在一个铁锈色的天空中昏暗地升起,照亮了水培田。在火星上的第一个永久栖息地,勇敢的探险家们刚刚醒来,开始另一个24.5小时的一天。
埃隆·马斯克认为,这样的场景是非常有可能的。
9月,这位SpaceX的创始人公布了他(仍然有点模糊的)的计划,在未来十年左右的时间里将人类送往火星,并指出到21世纪60年代,我们可能有一百万人在这颗红色星球上全职工作。更为保守的NASA则预计,第一个登上火星的人应该是在2030年左右。
我们必须开始行动。在定居者真正地开始建立生活之前,我们必须提前准备好维持火星人们生存所需要的一切。
这意味着我们将要向火星发射大量的生命支持设备、栖息地、能量生产系统、食品、以及开发出能够从空气中分离可供呼吸的氧气和饮用的水的技术。
这是一个巨大的挑战。
地球和火星之间的最短旅行时间大约是五个月,但是这种情形只有当行星彼此对齐才会发生,而且每两年才有一次机会。在最乐观的情况下,为了在2060年人类定居奠定基础,我们大约拥有22次理想的发射机会。
最近的ExoMars着陆器的失败案例告诉我们,在火星上着陆相当棘手:它有足够的重力使得飞船加速下降,但是如此稀薄的大气,使得降落伞还不足以将飞船降到足够低的速度。
曾经在火星上降落的最重的东西,是重达1吨的好奇号漫游车,它组合使用了降落伞、反推火箭以及被称为天空起重机的悬挂装置。
考虑到我们目前尚不清楚,该如何将一个比好奇号更重的东西降落在火星表面,规划者们的工作被迫中止了。
SpaceX计划使用一种称为超音速反向推进的技术,本质上来说,即通过发射加速火箭来减缓下降速度,并希望在2018年对该系统进行测试。NASA已同意对该项目施以援手,以换取一些从中学到的经验教训。
之前所说的这一切还没有包含旅程之中和登陆后的危险。
这其中包括高水平的辐射、太阳耀斑的威胁、低至-125℃的极端寒冷环境,以及可能覆盖太阳能电池板的尘埃——这些尘埃也有可能像玻璃碎片一样搅碎航天员的肺部。而且,我们还不知道该如何在那里种植食物。
但是,让我们先假设我们克服了所有这些挑战。那么接下来呢?太空探索的粉丝们喜欢指出,人类在历史上已经多次离开家园,去遥远甚至可能危险的地方寻找新的生活。登上探索新世界的大船,经常意味着你可能永远都不再会看到你的家园或家庭。
火星的不同之处在于,在那里除了尽量活下来以外,没有别的什么可以做。当欧洲探险家们走向美洲时,他们怀揣着能够找到能够卖回自己家乡的资源的希望,或者至少是一个建立农场的地方。火星上的资源少得可怜。在很长的一段时间里,第一批定居者们都将得不依赖他们的家园世界。而到2060年实现自给自足,看起来似乎是一个非常有野心的目标。
不过,定居者们还是可以做一件有用的事:科学。人类在一个小时内可以完成的研究需要耗费火星车好几个月的时间。当然,关于食物种植的研究会更加紧迫。
我们确实拥有这样一个遥远却而又无价的研究前哨的例子:南极洲。没有人永久地居住在那里,但人们短居在那里的一两年时间里,做了其他地方都不可能做到的科学研究。而火星可能正与此类似。
另一个与过去向遥远区域扩张不同之处在于,火星定居者们将与地球保持着持续的沟通,虽然受光速的限制,这种沟通将存在着几分钟的延迟。我们这些还在地球上的人们几乎肯定会看看他们的生活是如何开始的。我们能够看到所有进展顺利的一面,以及所有搞砸了的一面。
而接下来,我们是否进一步向太阳系推进,或者撤回地球则可能取决于这两件事的权衡。
如果我们能够想出如何在红色星球上获得食物和空气,以及相应的生活方式,我们似乎可以将这些想法应用于其他行星之上,或者更有可能就是身边的月球。我们能否成为一个多星球物种?火星将是我们的第一次大考验。
2076年的世界:再见电流,你好超导

对于一条大新闻来说,三十年的等待已经算得上是很长的时间了。
但是,在《新科学家》杂志的半生岁月里,已经有一小群研究人员非常确定,一个能够改变世界的发现即将到来。中国吉林大学的马彦明说,这一发现将给“我们的日常生活带来革命性变化”。
我们到底说的是什么突破?能够在室温和标准大气压下工作的超导体。我明白,这样的表达听起来很绕口,但是我会详细解释。
所谓超导体,是没有电阻的导电材料。这种现象最初是由荷兰物理学家海克卡·
莫林昂内斯(Heike KamerlinghOnnes)发现的。
他在1911年,发现汞在绝对零度以上4.2摄氏度时,其电阻下降到零。随后科学家们发现其他材料可以在稍高的温度下实现超导,但由于离不开极端制冷的环境,该现象的应用受到了很大的局限。
这一难题直到1986年才得以攻克。
那一年我们发现了高温超导体,其在大约100开尔文(这是-170°C:术语“高温”是相对的)的温度下实现了超导。猛然间,创造室温超导体似乎没有看起来得那么遥远。
但是,到目前为止,第二次巨大的飞跃还没有到来。
英国爱丁堡大学的保罗·艾菲特说,与30年前相比,我们并没有取得什么太大的进展。现在已经发现部分材料会在稍高的温度下超导,但前提是得施加非常高的压力。
目前而言,对于那些杀手级应用而言,超导仍然不是一个完全可行选项,尽管实现室温超导,将允许我们改变世界:包括运输和电力传输。
超导体是磁场的强势垒,意味着磁体将在它们上方悬浮。这使得他们非常适合用于打造高效和非常快速的磁悬浮列车,而不因受到摩擦造成能量损失。
能量损失——或者不存在能量损失——对于电力供应而言至关重要。当我们从发电站向消费者供电时,电流需要通过电缆传输,而电缆的电阻却阻碍这样的流动。其结果是,我们生产出的功率远远超过我们真正所需。
使用超导电缆,我们就都不会损失了。这也意味着使用超导材料的电池可以永久地充电。这两种技术将帮助我们解决世界上许多能源问题,而不必依赖于另一个伟大的未来能源革命——核聚变。
德国美因茨马克斯普朗克化学研究所的米凯海尔恩里梅茨(MikhailEremets)说:“人类将生活在一个超导的世界。”
恩里梅茨说,室温超导不存在基础的理论障碍。
8月,由位于纽约恩普顿的布鲁克海文国家实验室的伊万波兹维奇(Ivan Božović)领导的一个研究小组在《自然》杂志上发表了一篇开创性的论文,可能指出了新的方向。波兹维奇说道,“这表明,我们的追求中出现了一个战略性的变革,我对此感到很乐观。”
2076年的世界:人口崩溃

人口爆炸是否会以最意想不到的方式被触发?与马尔萨斯人口爆炸论相反,我们是否有可能正站在人口崩溃的悬崖边?
为了理解这是如何发生,以及为什么会发生,我们可以去日本看一看。最近的一项调查发现,那里的人们正在逐步放弃了性生活。
尽管人们的预期寿命为85岁而且这个数字仍然在不断增加,日本的人数正在下降,这主要应归因为了每个妇女只有1.4个孩子的生育率,以及据报道日益增长的童贞数量。人们似乎太忙了(也太害羞),而顾不上生育。
这个结果引人注意。欧洲和远东的国家也正在徘徊在人口悬崖上,生育率低于1.5。根据最近的趋势,在未来60年内,德国和意大利的人口数量将减半。
世界已经达到其儿童数量的峰值,在瑞典斯德哥尔摩卡洛琳卡学院(Karolinska Institute)的汉斯·罗斯林(Hans Rosling)说。人口的高峰也即将到来。
当下而言,世界人口继续攀升。由于非洲的高生育率,我们的人口可能会从今天的74亿人,增长到90亿左右。联合国预测人口将持续上升,并在2100年,人口数量达到约112亿。但这似乎不太可能发生。在人口低迷之后,没有一个国家的生育力能够得以恢复。许多人口学家预计,到2076年全球将会崩溃。
政府可能在试图阻止这样的下降趋势——虽然在新加坡,人们已经尝试了整整一代人,但是新加坡仅为0.8的生育率仍然为世界上最低。一旦能够生育的妇女人数开始下降,扭转这一趋势将非常困难。人口增长将变成衰落。
这对人类的未来而言,意味着什么? 到2076年,孩子们将成为稀罕物。在历史上第一次,绝大多数人口都是老年人。而20世纪那样疯狂的、激素驱动的文化似乎注定要衰败了,创新也因此而可能会枯竭。
它也可能会破坏我们的经济。一些经济学家说,自从1990年代以来,日本一再的经济衰退是因为越来越多的老人平添了负担。也许欧洲也是这样。中国可能会是下一个,因为其人口将在2030年达到顶峰。人口决定论者担忧我们的物种处于一个缓慢的下降螺旋。人类灭绝的原因可能不是因为人口爆炸,而是失禁后的呜咽。
当然,也许可能现实并不会这样糟糕。银发社会肯定会有所不同。但也许,像那些上了年纪的摇滚明星那样,我们会发现,老了也并不是那么坏,老人也可以重新变得年轻。而且老年社会不容易拿起武器。一个拥有更少人类的社会也会给地球的生态系统一个喘息的机会。
或许,马尔萨斯的观点将不会再被提及。相反,生态学家爱德华·威尔逊呼吁,长达一个世纪的生态恢复可能会到来。至少,大自然也许会享受好的这一面。
2076年的世界:文明比我们想象的更脆弱

现在这个星球上有74亿人——这几乎是60年前的三倍。联合国估计,在接下来的一个60年时间里,我们的人口将接近110亿。但也有人指出,受资源限制,地球人口数量将达到峰值,然后逐渐下降。
其实还有另一种可能性:面临资源的限制,会使我们脆弱到令人惊讶的文明崩溃,并引发全球性的灭绝。
文明可能看起来很强大,但它实际上更像是一个杂耍行为。我们使用密切联系网络,将制造、贸易、金钱、就业、食品、水、运输、能源、技术、医疗保健、地缘政治和法律和秩序等联系在一起,就像是把所有的球都扔在空中。每个网络借由许多反馈回路,与所有其他网络彼此依赖。
换句话说,文明是一个适应性的、复杂的系统——这种系统容易遭受灾难性的失效。
在马萨诸塞州剑桥的新英格兰综合系统研究所的亚尼尔巴亚姆(Yaneer Bar-Yam)说,任何重要的子系统的失效都会导致整个大楼崩溃。即使是小故障也可能造成很大的麻烦。正如我们在2008年看到的那样,当地方财务失败通过耦合系统级联,导致了全球金融危机,而我们现在仍然能感受到这次危机的余波。
就文明本身而言,我们不清楚哪个子系统失效,或者多严重的失效,将使我们陷入严重的麻烦。但我们可能知道一些会引发崩溃的因素。
举个例子来说,如果全球变暖,导致甲烷从冻结的沉积物释放,我们将面临正反馈:进一步升温,导致进一步的气体释放,最终导致温度升高完全失控。面对天气,病虫害以及疾病等的快速变化,农业系统将会崩溃。数百万人会饿死。而其他的主要风险还有核战争和全球流行病。
除了夺走数以百万计的生命之外,这些情形还可能触发社会的总崩溃。经济体系对于失去那些起到“枢纽”作用的关键工人非常敏感,如卡车司机和炼油厂操作员。
举例而言,与1918年那场流感具有相近死亡率的流行疾病将使得许多对食物供应、民事秩序、运输、电力和许多其他支持系统至关重要的关键人物退出工作岗位。随着事态的进一步失控,越来越多的人死于越来越多的原因,导致越来越多的子系统失效,并最终进一步地加速了崩溃的发生。
难道我们不能只是暂时偃旗息鼓,当风暴结束时像往常一样回去工作?
问题是,一旦复杂的系统崩溃,它将保持着崩溃的状态。历史的进程告诉我们,我们之前的一个不那么复杂而可替代的稳定状态将重新出现。它可能是小型的、专制的城市国家,或甚至重新回到狩猎和群居时代。
这个故事的意义究竟何在?我们需要为大型流行病、温室气体排放、核扩散等做好准备。最重要的是,我们要认识到,一个紧密耦合的全球社会其实很脆弱。
2076年的世界:反科学的反弹已经开始

在1957年约翰·冯·诺伊曼逝世后,他的朋友和合作者斯坦尼斯瓦夫·乌兰姆(Stanislaw Ulam)写过一篇悼文,向在战后在世界上推动科学和技术进步做出了最大贡献的这个人致敬。
乌拉姆回忆说,冯诺依曼担心科学失去公众支持:“人类的利益可能改变,而大众对科学的好奇心可能停止,并且未来人类的思想可能被完全不同的事情所占据。”
冯·诺依曼太过于悲观了:过去60年来,科学技术的进步令人震惊。但时代在变化,公众的态度也充满变数。他的预测会在将来成真吗?
研究科技政策影响与观点的伦敦大学学院的杰克·斯蒂尔格(Jack Stilgoe)说,“我确实担心公众舆论有可能会转向。”如果人们认为创新会逐渐远离其本质,让富人更加富有,而其他社会需求却被忽视,那么他们很可能就会失去兴趣。
当机器人接手我们的工作,或者当保险公司因为人类已经成了最危险的马路杀手,而索求巨额保费时,我们仍然会喜欢技术吗?人们会砸烂自助驾驶的出租车吗?就像卢德成员攻击自动织布机那样?
在一些小的、充满愤怒的角落,这样的反弹思潮已经羽翼渐丰。前数学家泰德卡兹尼斯基(Ted Kaczynski,又名炸弹客)刚刚出版了一本名为《反科技革命》的书。
英国华威大学的社会学家史蒂夫·富勒说:“他似乎认为,唯一的办法就是大幅度缩减我们的科学和技术野心,即使这可能导致人类生活方式的急剧倒退。这本书写得合情合理。这本书写得就像他在指示一个充满革命斗志的细胞如何阻止科学和技术破坏地球。”
斯蒂尔格则对此持怀疑态度。他认为,富国的社会已经变得非常依赖科学和技术,所以真的不太可能发生。但如果确实发生,后果将是可怕的。
哈佛大学历史学家马修·赫施(MatthewHersch)表示,公众情绪的改变会阻碍一切形式的科学研究,这将导致技术和经济的停滞,而我们将面临技术和金融的破坏。
他指出,同样可怕的还有社会的动荡。
当大学和学院的教职员工停止学习新事物,从错误百出的教科书里,他们提供的教育将萎缩和退化成为教条、似是而非以及未经测试的假设。
2076年的世界:我们修复了气候,但是仍然面对威胁

现在是2076年,天空看起来确实是乳白色的。在刮着大风的平原和海洋上,人类搭建了风电农场。但在这些涡轮机边上,人们还建造了一种不同类型的塔,并从空气中吸收二氧化碳。
于是,一大块土地成为了森林。在发电场中种植的树木,在生长、收获、以及燃烧过程之中,都不会让二氧化碳排放到大气中。
相反,排放的二氧化碳将被捕捉,并泵送到地下储存容器中。船舶将粉状矿物倾倒在海洋中,使其吸收二氧化碳,并减少海洋酸化。
所有这些技术都是为了扭转长达两个多世纪温室气体排放而做的绝望补救。但他们尚未能完成这一目标,我们反而仍然在排放温室气体。
所以,在10公里至18公里的大气中,一层细微的粒子屏蔽了太阳向地球的照射,并使我们的环境保持凉爽。这也是为什么天空有点发白的原因。
英国南安普敦大学的约翰·谢普德说:“我认为,在60年后,我们很有可能将使用这两种技术。”他指的是两种风格截然不同的地球工程计划:从空气中吸收二氧化碳,并使用遮阳罩将一些太阳光线弹回宇宙中。
像许多气候科学家一样,谢普德认为气候谈判进展得太慢。即使工业排放量能够迅速下降,尽管即使这一点还要打上一个大大的问号,还有其他的方面造成的棘手问题。我们没有飞机燃料的替代产品,而供养众多的人类需要精耕细作的农业,而这两者占据了全球二氧化碳排放量的四分之一。
这就是为什么我们必须从空气中吸收二氧化碳。因为这是一个很难实现的目标,我们可能还要依靠“太阳辐射管理”。
研究中最多出现的想法,是将硫酸盐细颗粒喷入平流层,但人们对于其后果仍然知之甚少。电脑模型表明,最终世界上会分为赢家和输家。虽然遮阳方案可以将全球平均气温降低到工业化前的水平,但这会带来区域差异。北欧、加拿大、西伯利亚和两极将比之前更加温暖,而海洋上的温度将降低。
人们预计,全球变暖将使得湿润地区变得更潮湿,而干燥的区域更干燥。电脑模型指出,遮阳罩可能可以改善这一点,但是,这样的改善仍然不是均匀的。仰赖这季节性降雨的热带区域由于季风变干,可能会遭受的最大的影响。
谢普德担心,所有这些将会引起国际争端。他设想了一种全球性的理事会,而政府可以根据满足本国需求的气候而进行游说。为了旅游业或者农业,有些人可能更加青睐温暖的气候。但是依赖珊瑚礁吸引游客的国家则可能需要更多的CO2吸收技术来抵御海洋酸化和漂白。
最后是一个苦涩的转折。飞上天的东西最终都会降下来,所以人们将不得不不断补充遮阳罩。比如说,一些国际地球工程协议的完全崩溃这样的事情发生之后,我们停止喷洒硫酸盐,后果将是灾难性的。
在十年到二十年的时间内,没有遮阳罩的地方温度将会飙升。原来温暖的地区会变得超级热,谁也不知道我们将面临的是什么临界点。后果之严重,几乎不值得我们去考虑。
2076年的世界:无论机器多聪明,人类仍将是主宰

无论你怎样看,未来似乎都前景黯淡。在环境、经济和政治等方方面面,世界似乎都面临着巨大的压力。
表面上,我们在未来面临的威胁数不胜数:一个巨大的小行星撞击、全球变暖、一种新型瘟疫、或者是把一切变成灰色的粘土的离经叛道的纳米机器人。实际上,我们都不太确定究竟该最害怕什么,甚至未来人类是否还存在都是一个大大的问号。
但这几年,我们讨论最多的一个潜在威胁则是人工智能。2014年12月,史蒂芬·霍金告诉英国广播公司,“全人工智能的发展可能会导致人类的终结……它将自己能发展自己,并以不断增长的速度重新设计自己。受到缓慢的生物进化限制的人类,将无法与之竞争,并最终将被取代。”
去年,他接着这一话题对媒体表示,人工智能有可能是“发生在人类头上最好的或最坏的事”。
其他的知名人士,包括埃隆·马斯克、比尔·盖茨和史蒂夫·沃兹尼亚克,对于人工智能可能对人类造成的风险也作了类似的预测。然而,数十亿美元仍旧滚滚地流入人工智能领域的研究中,并且这一领域正在取得惊人的进步。
在今年3月份的一场堪称里程碑的比赛之中,围棋大师李世石以1-4的比分落败于AlphaGo计算机。在许多其他领域,无论是在地面驾驶出租车还是在空中赢得格斗,计算机正逐步开始接管人类。
理论上,霍金的恐惧源自于技术奇点这一想法。在该语境中,奇点是指机器智能开始跨越式发展的时间点,同时也是一个更为智能的新型物种开始统治地球的起点。技术奇点这一想法可以追溯到许多早期的思想家,其中包括计算的创始人之一约翰·冯·诺伊曼(John von Neumann)和科幻作家弗诺文奇(Vernor Vinge)。
有趣的是,这个想法的历史大致与AI研究本身相近。在1958年,数学家斯坦尼斯瓦夫·乌兰姆(Stanislaw Ulam)在悼念不久之前逝世的冯·诺伊曼的文章中,他回忆道:“(我们有过)一次对话,对话的中心是不断加速的技术进步和人类生活方式的变化,而这些变化促成了一些奇点基础观点的雏形……我们那时候的理解是,奇点之后,人类的事务将无法继续。”
最近,技术奇点的想法受雷·库兹韦尔(RayKurzweil)的推广而广为人知。他预测,技术奇点将在2045年左右发生,而尼克·博斯特鲁姆(Nick Bostrom)已经写了一本介绍后果的畅销书。
我们害怕机器超越我们的智力有如下几个原因。人类之所以能够成为地球上的最具有统治力的物种,最主要是因为我们拥有无可比拟的智力优势。许多动物比我们体型更大,更快或更强,但我们利用我们的智慧发明了工具,发展了农业,并开发出许多惊人的技术,比如蒸汽机、电机和智能手机。我们的生活由此改变,并使得我们得以统治地球。
因此,具有思考能力的、甚至思考能力可能比人类还要强大的机器未来很有可能将篡夺人类的位置——这一想法毫不意外,就正如大象、海豚和熊猫依靠我们的善意继续存在,而我们的命运则反过来有可能取决于这些高级思维机器的决定。
智力爆炸这一观点,即机器能够递归般提高它们的智力,从而迅速超过人类智力,其实并不是一个特别疯狂的想法。
从许多类似的指数趋势中,计算领域获益匪浅。摩尔定律预测集成电路上的晶体管数量每两年将增加一倍,这是过去几十年来的现实。因此,假设AI也将经历指数增长并不是不合情理的。
像许多在 AI 领域工作的同事一样,我们预测,距离AI达到甚至超越人类的智力水平仅仅只需30年到40年即可。
总之,我们认为,技术奇点是不可能实现的。
来源:DeepTech深科技


